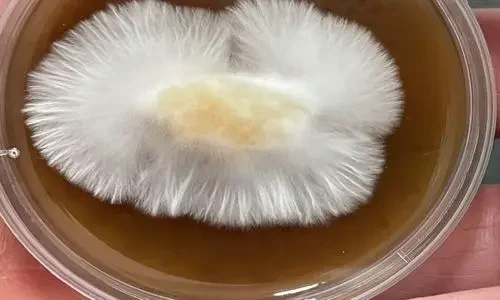
micelio psilocibe

Gana dinero cultivando hongos
Aprender a cultivar setas es solo el principio. El reto es convertirlo en un negocio rentable.

Empieza un negocio rentable de setas
Aprende a instalar un cultivo comercial de setas y a obtener clientes. Perfecto para emprendedores que quieren iniciar su propio negocio de producción a pequeña escala.
- Empieza con poca inversión, usando materiales fáciles de conseguir
- No necesitas experiencia; te enseño paso a paso.
- Protocolos probados para lograr tu primera cosecha rápido.
- Para cultivar seta de ostra u orellana y aprender los fundamentos del cultivo de cualquier tipo de seta
- Donde encontrar clientes y como llegar a ellos.
Técnicas de Laboratorio para Cultivadores
Domina las técnicas esenciales de laboratorio para garantizar cultivos exitosos y libres de contaminación. Ideal para quienes buscan profesionalizar su producción.

Producción Semi Industrial de Micelios
Escala tu producción con técnicas semi-industriales de producción de micelios. Aprende a optimizar procesos para aumentar tu capacidad productiva.

Tu Instructor Especializado
Soy Buenaventura Rodríguez, Licenciado en Biología Celular y Molecular con 12 años de experiencia en el cultivo de hongos comestibles y desarrollo de técnicas de laboratorio.

Mi especialización en cultivo de setas y técnicas de laboratorio me ha permitido desarrollar métodos únicos que comparto en mis cursos.
Además soy administrador de empresas desde 1990, especializándome en el área de ventas y marketing. He fracasado en muchos negocios (y acertado en alguno), con lo que puedo aumentar las posibilidades de éxito de tu emprendimiento.
